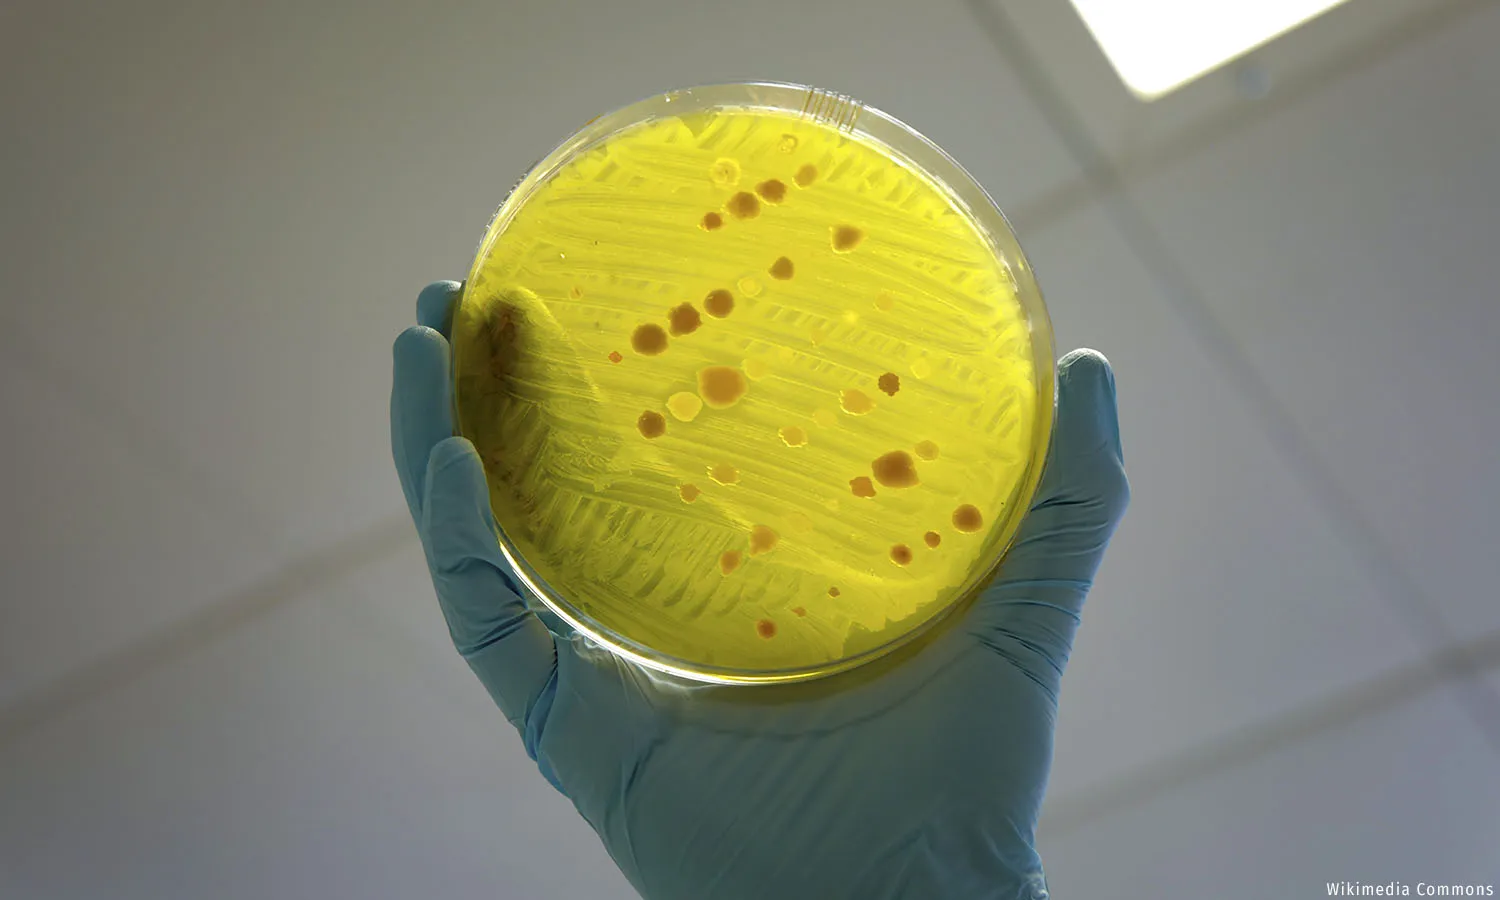

You Searched For "pandemic"
#DataViz: School Performance Grading Reveals Poor Learning Outcomes Across India
The ‘ultimate goal’ of the index is improving student learning outcomes, but the pandemic has negatively impacted students' learning and children are...
India Must Act Swiftly To Stop This ‘Silent Pandemic’ From Becoming Catastrophic
By 2050, #AntimicrobialResistance is expected to claim 10 million lives a year globally, more than cancer and diabetes combined, with most of this...